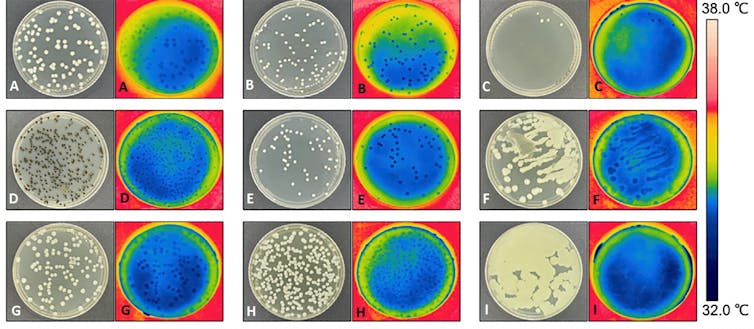

Los hongos también sudan
El descubrimiento de que los hongos pueden regular su temperatura “sudando” revela un proceso fisiológico aparentemente universal que hasta ahora no había sido investigado en esos organismos.

El descubrimiento de que los hongos pueden regular su propia temperatura enfriándose con sudor revela un proceso fisiológico aparentemente universal que hasta ahora no había sido investigado en esos organismos.
En el reino Fungi, el reino de los hongos, se han descrito más de 150 000 especies, incluidas las macroscópicas como los hongos micorrizógenos productores de cuerpos fructíferos (las conocidas setas) y las microscópicas como mohos y levaduras. Unos y otros juegan un papel central en el equilibrio ecológico de la Tierra.
A diferencia de lo que ocurre con animales y plantas, la temperatura corporal y la termorregulación de los hongos son relativamente desconocidos. Los resultados de una reciente investigación demuestran que no solo los hongos formadores de cuerpos fructíferos (setas), sino también las colonias microscópicas de levaduras y mohos pueden mantener temperaturas más frías que su entorno.
La vida y la segunda ley de la termodinámica
Como consecuencia del hecho de que el universo comenzó en un estado de baja entropía y aún no ha alcanzado el equilibrio, todas las formas de vida son sistemas disipativos alejados del equilibrio termodinámico. Esto significa que pueden estar más calientes o fríos que su entorno.
La homeostasis es una propiedad de los organismos que consiste en su capacidad de mantener una condición interna estable compensando los cambios en su entorno mediante el intercambio regulado de materia y energía con el exterior (termorregulación metabólica). Esto hace que la temperatura de cualquier organismo dependa del equilibrio entre la producción, la ganancia y la disipación de la energía calorífica.
La forma de obtener calor puede ser por endotermia o por ectotermia. Los organismos endotermos u homeotermos (del griego homeo, parecido) controlan la temperatura corporal mediante la producción interna de calor, y mantienen habitualmente dicha temperatura por encima de la temperatura ambiental. Para regular su temperatura corporal, los organismos ectotermos o poiquilotermos (del griego poikilos, variedad) dependen, fundamentalmente, de una fuente de calor externa.
Endotermos y ectotermos usan el sudor para evaporar el agua de sus superficies, gracias a lo cual emiten calor y se enfrían. La evaporación del agua es un proceso endotérmico que consume energía para romper los puentes de hidrógeno cuando el agua pasa de líquido a gas. Los estomas de las plantas terrestres regulan el proceso de transpiración abriéndose y cerrándose en respuesta a estímulos. El enfriamiento por evaporación en los animales se logra a través de las glándulas sudoríparas.
La regulación térmica de los hongos

Luis Monje
Aun careciendo de estomas o de glándulas sudoríparas, los cuerpos fructíferos o esporocarpos de los hongos (setas) se enfrían mediante la evapotranspiración del agua de su superficie. En otras palabras: sudan.
La relevancia biológica de la temperatura relativamente fría de los píleos de las setas, cuya tasa de pérdida de agua puede ser mayor que la de las plantas y suficiente para enfriar el aire circundante en varios grados centígrados, se relaciona con la dispersión de las esporas.
A diferencia de la bien conocida regulación térmica de los hongos macroscópicos con esporocarpos y de animales y plantas, la de las comunidades de hongos microscópicos, protistas, arqueas y bacterias está poco estudiada, aunque debido a su pequeño tamaño (o alta relación superficie/volumen), se supone que los microorganismos son seres ectotérmicos cuya masa térmica individual es insuficiente para mantener una diferencia de temperatura con respecto a su entorno.
Sin embargo, los microorganismos suelen vivir en comunidades, lo que hace muy factible que, agrupados, sean capaces de modificar su temperatura. Como desde hace una década se sabe que las colonias de la bacteria Pseudomonas putida producen calor, es posible que cualquier otra comunidad microbiana pueda producir suficiente energía térmica interna para mantener temperaturas más cálidas que el entorno.
Además, el hallazgo de que las mitocondrias tienen temperaturas cercanas a los 50 °C sugiere la posibilidad de que existan motores térmicos a nanoescala, aunque lograr temperaturas tan altas en los orgánulos plantee varios enigmas físicos.
Termogramas fúngicos
Para comprobar si los hongos desprenden calor, los autores de la citada investigación aplicaron tecnologías termométricas para medir la temperatura de hongos macroscópicos en su hábitat natural y de colonias de hongos microscópicos cultivados en laboratorio.

Modificada a partir de Cordero et al. 2023.
Los termogramas resultantes demuestran que la hipotermia inducida por evapotranspiración parece ser una característica general de todo el reino Fungi. Los termogramas de veinte especies de hongos que crecen en plena naturaleza revelan temperaturas superficiales más frías que el aire circundante. Como media, dependiendo de la especie, los hongos estaban entre 2,9 ± 1,4 °C más fríos que el aire a su alrededor.
Las colonias de quince especímenes de levaduras y mohos estaban más frías (entre 0,3 y 1,9 °C más frías dependiendo de la especie) que el agar de los márgenes. La capacidad de refrigeración de los cultivos de hongos puede utilizarse experimentalmente para fabricar refrigeradores naturales.
Modificada a partir de Cordero et al. 2023.
Esta investigación confirma que los hongos macroscópicos, los mohos y las levaduras son hipotérmicos, es decir, están más fríos que su entorno, lo que sugiere que el enfriamiento relativo es una propiedad general del reino Fungi. Los hongos unicelulares logran la hipotermia gracias al enfriamiento por evaporación como hacen los hongos macroscópicos, lo que permite pensar que, evolutivamente, este mecanismo de enfriamiento sea un sistema de termorregulación ancestral.
Saber cómo las temperaturas de los hongos varían con su nicho ecológico implica múltiples variables que requieren más investigación, porque conocer la razón que subyace en este fenómeno de enfriamiento podría ayudarnos a entender cómo interactúan los hongos con su entorno y con otros organismos, incluidos los seres humanos, muy afectados por enfermedades fúngicas que cada año matan a más de 1,5 millones de personas.
Algunas investigaciones recientes sugieren que el aumento de las temperaturas globales podría incrementar el número de especies fúngicas potencialmente causantes de infecciones humanas graves que obligan a plantear nuevos escenarios pandémicos.

Modificada partir de Cordero el al. 2023.
Por el momento, los humanos tenemos cierta protección contra las infecciones por hongos, ya que estos no crecen bien con nuestra temperatura corporal. Pero con el cambio climático, los patógenos podrían comenzar a adaptarse a temperaturas más cálidas para permitirles infectar a los humanos más fácilmente. La nueva investigación sobre la poiquilotermia de los hongos plantea más preguntas que respuestas.
Manuel Peinado Lorca, Catedrático de Universidad. Director del Real Jardín Botánico de la Universidad de Alcalá, Universidad de Alcalá y Luis Monje, Biólogo. Profesor de fotografía científica, Universidad de Alcalá
Este artículo fue publicado originalmente en The Conversation. Lea el original.
- Me gusta 0
- Me encanta 0
- Me divierte 0
- Me asombra 0
- Me entristece 0
- Me enoja 0